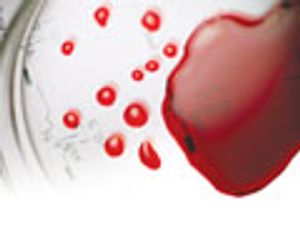
On-line Whole Blood Analysis using Microextraction by Packed Syringe (MEPS) and LC–MS–MS

In this article, two sample handling and sample preparation methods for saliva samples are presented and discussed. Both methods were applied for determining the presence of lidocaine in saliva.

In this article, two sample handling and sample preparation methods for saliva samples are presented and discussed. Both methods were applied for determining the presence of lidocaine in saliva.

A new sample preparation method is described for whole blood sample analysis in clinical and preclinical studies.

Microextraction by packed sorbent is a sample preparation technique that can be connected on-line with LC or GC systems.

Microextraction by packed sorbent (MEPS) is a new technique in sample preparation that can be connected on-line to gas chromatography (GC) or liquid chromatography (LC) without any modifications.

Published: April 1st 2011 | Updated:
Published: July 1st 2011 | Updated:

Published: January 1st 2009 | Updated:

Published: October 1st 2014 | Updated: